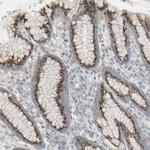
GALNT6 Antibody in Immunohistochemistry (IHC)

Search
Invitrogen
GALNT6 Polyclonal Antibody
{{$productOrderCtrl.translations['antibody.pdp.commerceCard.promotion.promotions']}}
{{$productOrderCtrl.translations['antibody.pdp.commerceCard.promotion.viewpromo']}}
{{$productOrderCtrl.translations['antibody.pdp.commerceCard.promotion.promocode']}}: {{promo.promoCode}} {{promo.promoTitle}} {{promo.promoDescription}}. {{$productOrderCtrl.translations['antibody.pdp.commerceCard.promotion.learnmore']}}
产品信息
PA5-52852
种属反应
宿主/亚型
分类
类型
抗原
偶联物
形式
浓度
规格
纯化类型
保存液
内含物
保存条件
运输条件
RRID
产品详细信息
Immunogen sequence: LIMYSCHGLG GNQYFEYTTQ RDLRHNIAKQ LCLHVSKGAL GLGSCHFTGK NSQVPKDEEW ELAQDQLIRN SGSGTCLTSQ DKKPAMAPCN PSDPHQLWLF V
Highest antigen sequence identity to the following orthologs: Mouse - 85%, Rat - 83%.
靶标信息
This gene encodes a member of the UDP-N-acetyl-alpha-D-galactosamine:polypeptide N-acetylgalactosaminyltransferase (GalNAc-T) family of enzymes. GalNAc-Ts initiate mucin-type O-linked glycosylation in the Golgi apparatus by catalyzing the transfer of GalNAc to serine and threonine residues on target proteins. They are characterized by an N-terminal transmembrane domain, a stem region, a lumenal catalytic domain containing a GT1 motif and Gal/GalNAc transferase motif, and a C-terminal ricin/lectin-like domain. GalNAc-Ts have different, but overlapping, substrate specificities and patterns of expression. The encoded protein is capable of glycosylating fibronectin peptide in vitro and is expressed in a fibroblast cell line, indicating that it may be involved in the synthesis of oncofetal fibronectin.
仅用于科研。不用于诊断过程。未经明确授权不得转售。
篇参考文献 (0)
生物信息学
蛋白别名: GalNAc transferase 6; GalNAc-T6; Polypeptide GalNAc transferase 6; Polypeptide N-acetylgalactosaminyltransferase 6; pp-GaNTase; pp-GaNTase 6; Protein-UDP acetylgalactosaminyltransferase 6; UDP-GalNAc:polypeptide N-acetylgalactosaminyltransferase 6; UDP-N-acetyl-alpha-D-galactosamine: polypeptide N-acetylgalactosaminyltransferase 6; UDP-N-acetyl-alpha-D-galactosamine:polypeptide N-acetylgalactosaminyltransferase 6 (GalNAc-T6); unnamed protein product
基因别名: GALNAC-T6; GalNAcT6; GALNT6
UniProt ID: (Human) Q8NCL4
Entrez Gene ID: (Human) 11226